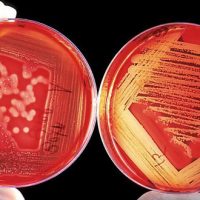

Κλινικές δοκιμές με αίμα που δημιουργήθηκε στο εργαστήριο ξεκινούν ερευνητές από τη Βρετανία -μια μελέτη που μπορεί να φέρει πραγματική ιατρική «επανάσταση», εάν όλα εξελιχθούν θετικά. Όπως μεταδίδει το BBC, οι ερευνητές θα χορηγήσουν μικρή ποσότητα του τεχνητού αίματος -μόλις μερικές κουταλιές- σε εθελοντές, και στη συνέχεια θα μελετήσουν πώς θα ανταποκριθεί ο οργανισμός τους. Πρόκειται για μια κοινή προσπάθεια ερευνητών από το Μπρίστολ, το Κέιμπριτζ, το Λονδίνο αλλά και…
Read MoreΕτικέτα: ΕΡΓΑΣΤΗΡΙΟ
Ηράκλειο: Διέγνωσαν ότι ετοιμόγεννη είχε κορονοϊό, χωρίς να έχει! – Μέσα σε 3 ώρες άλλαξαν τα αποτελέσματα του τεστ!
Το περιστατικό σημειώθηκε πριν από λίγες ημέρες στο Ηράκλειο και, όπως θα διαπιστώσετε, προκαλεί πολλά ερωτηματικά. Σύμφωνα με πληροφορίες του Candiadoc, έγκυος μεταφέρθηκε σε ιδιωτική κλινική της πόλης προκειμένου να γεννήσει. Όπως ορίζει η διαδικασία, η γυναίκα υποβλήθηκε σε μοριακό τεστ το οποίο ελέγχθηκε στο Εργαστήριο Κλινικής Ιολογίας της Ιατρικής Σχολής του Πανεπιστημίου Κρήτης, που λειτουργεί υπό τον καθηγητή Γ.…
Read MoreΡωσία: Έκρηξη σε εργαστήριο που φυλάσσονται ιοί της Ευλογιάς και του Έμπολα
Έκρηξη αερίου που προκάλεσε πυρκαγιά, σημειώθηκε σε ρωσικό εργαστήριο που φυλάσσει ιούς, όπως η ευλογιά και ο Έμπολα. Η έκρηξη σημειώθηκε κατά τη διάρκεια επισκευαστικών εργασιών στον πέμπτο όροφο του Κρατικού Ερευνητικού Κέντρου Ιολογίας και της Βιοτεχνολογίας στην περιοχή Νοβοσιμπίρσκ της Σιβηρίας. Ο χώρος χρησιμοποιείται για την εκπόνηση ερευνών σχετική με βιολογικά όπλα κατά την περίοδο της Σοβιετικής Ένωσης και σήμερα…
Read MoreΓια πρώτη φορά δημιουργήθηκαν στο εργαστήριο τέλεια ανθρώπινα αιμοφόρα αγγεία
Επιστήμονες ανακοίνωσαν ότι κατάφεραν για πρώτη φορά να αναπτύξουν στο εργαστήριο τέλεια ανθρώπινα αιμοφόρα αγγεία. Το επίτευγμα αποτελεί σημαντικό βήμα προόδου για την αξιοποίηση τέτοιων οργανοειδών όπως αποκαλούνται, προκειμένου στο μέλλον να αντιμετωπισθούν διάφορες αγγειακές παθήσεις σε ασθενείς όπως οι διαβητικοί. Οι ερευνητές από τον Καναδά, τις ΗΠΑ, την Αυστρία και τη Βρετανία, με επικεφαλής τον δρα Γιόζεφ Πένινγκερ, διευθυντή…
Read MoreΕργαστήριο δημιουργικής ανακύκλωσης στον ΕΣΔΑΚ για χριστουγεννιάτικες διακοσμήσεις
Όλα είναι έτοιμα για ένα ακόμα Εργαστήριο Δημιουργικής Ανακύκλωσης στον Ε.Σ.Δ.Α.Κ., το οποίο θα πραγματοποιηθεί από την Όλγα Χρήστου την Τρίτη 11 και την Τετάρτη 12 Δεκεμβρίου 2018, από τις 17:30 έως τις 20:00, στα γραφεία του Ε.Σ.Δ.Α.Κ. στο Ηράκλειο (Λ. Αρχιεπισκόπου Μακαρίου 22 & Σκουλάδων, στον 3ο όροφος). Οι συμμετέχοντες θα κατασκευάσουν εύκολα Χριστουγεννιάτικα διακοσμητικά από χαρτί και αλουμινένια…
Read MoreΒρήκαν εργαστήριο που τύπωνε σήματα – «μαϊμού» από μεγάλες φίρμες
Εργαστήριο στη Θεσσαλονίκη στο οποίο τυπώνονταν σήματα επώνυμων εταιριών σε ενδύματα εντόπισε το ΣΔΟΕ. Στην ανακοίνωσή του το ΣΔΟΕ κάνει λόγο για ακόμη ένα σοβαρό πλήγμα στα κυκλώματα διακίνησης και εμπορίας παραποιημένων προϊόντων που επέφεραν υπάλληλοι της Επιχειρησιακής Διεύθυνσης Σ.Δ.Ο.Ε. Μακεδονίας, στην προσπάθεια αντιμετώπισης του οργανωμένου οικονομικού εγκλήματος, της απάτης σε βάρος των συμφερόντων του ελληνικού δημοσίου και της Ε.Ε.…
Read MoreΜε επιτυχία το εργαστήριο δημιουργικής ανακύκλωσης στη Ροδιά
Με τη συμμετοχή γονέων και παιδιών, πραγματοποιήθηκε ένα ακόμα εργαστήριο δημιουργικής ανακύκλωσης μαζί με εκδήλωση ενημέρωσης και ευαισθητοποίησης για την μείωση της χρήσης της πλαστικής σακούλας, στη Ροδιά. Έπειτα από πρωτοβουλία του δραστήριου Συλλόγου Γονέων και Κηδεμόνων του οικισμού, η Δρ Χημικός Μηχανικός και πρώην στέλεχος του Ε.Σ.Δ.Α.Κ. Όλγα Χρήστου, παρουσίασε στους μικρούς και συμμετέχοντες όμορφες και χρηστικές κατασκευές φτιαγμένες…
Read MoreΤαχύρρυθμο εργαστήριο δημιουργίας ταινιών stop motion animation για εκπαιδευτικούς στο Ηράκλειο
Το Γραφείο Σχολικών Δραστηριοτήτων Δ.Δ.Ε. Περιφερειακής Ενότητας Ηρακλείου (Υπεύθυνη Αγγελική Ζαχαράτου) με την υποστήριξη του Κοινωνικού Χώρου των Ιδρυμάτων Καλοκαιρινού διοργανώνουν «Ταχύρρυθμο εργαστήριο (8) ωρών δημιουργίας ταινιών stop motion animation για εκπαιδευτικούς σχολείων Δ.Δ.Ε. Περιφερειακής Ενότητας Ηρακλείου, σχολικού έτους 2017-2018» με εισηγητή τον Γιώργο Νεονάκη, φοιτητή Τεχνολογικού Πανεπιστημίου Κύπρου-graphic designer. Το α΄μέρος του εργαστηρίου πραγματοποιήθηκε τη Δευτέρα 8 Ιανουαρίου 2018,…
Read More